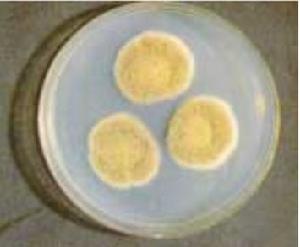
普通青黴

普通青黴
| 拉丁綱名 | Fungi Imperficti |
| 中文綱名 | 半知菌綱 |
| 拉丁目名 | Sphaeropsidales |
| 中文目名 | 殼霉目 |
| 拉丁科名 | Discellaceae |
| 中文科名 | 杯霉科 |
| 拉丁名 | Penicillium commune |
| 中文名 | 普通青黴 |
| 定名人 | Thom |
| 參考文獻 | Discellaceae |
 普通青黴
普通青黴 普通青黴
普通青黴
普通青黴,屬於殼霉目,杯霉科,拉丁名為Penicillium commune。
| 拉丁綱名 | Fungi Imperficti |
| 中文綱名 | 半知菌綱 |
| 拉丁目名 | Sphaeropsidales |
| 中文目名 | 殼霉目 |
| 拉丁科名 | Discellaceae |
| 中文科名 | 杯霉科 |
| 拉丁名 | Penicillium commune |
| 中文名 | 普通青黴 |
| 定名人 | Thom |
| 參考文獻 | Discellaceae |
普通青黴
普通青黴 普通青黴
普通青黴一、植物學 一、葉的形態 一、種子的形成
圖書信息 作者簡介 內容簡介 目錄、碳青黴烯類和青黴烯類酶抑制劑等。β-內醯胺類抗生素(β-lactams...感染的首選藥物。但是青黴素有不耐酸、不耐青黴素酶、抗菌譜窄和容易引起...6-氨基青黴烷酸(6-APA),進行化學改造,接上不同側鏈,合成了幾百種...
簡介 作用機制 影響因素 耐藥機制 青黴素類歧桿菌產酸較慢,所以雙歧桿菌通常和普通的優酪乳菌種一起使用來製作優酪乳。然而...黴菌經常套用於乾酪生產,它們是白青黴和藍青黴。常用的白青黴 ...
發酵劑菌種分類 菌種的選擇 發酵劑菌種的分離、鑑別與活化麴黴、赭麴黴、孔麴黴、佩特麴黴和菌核麴黴等。青黴屬有:徘徊青黴、鮮綠青黴、普通青黴、變幻青黴、產紫青黴、圓弧青黴和產黃青黴等。(二)赭麴黴毒素...,OTA)是毒性最強的成分。(一)主要產毒菌株赭麴黴毒素是由麴黴屬和青黴...
赭麴黴毒素(Ochratoxin) 赭麴黴毒素脫毒介紹普通的烹飪可以殺死的,而且是不易被探測到的,只能通過一些分析手段才能發現...
食品污染物 分類 微生物危害物 最大殘留限量(MRL) 日允許攝入量(ADI)青黴、白色念珠菌、藤黃微球菌、表皮葡萄球菌、糞鏈球菌、吸水鏈黴菌、普通...6月,菌種保藏中心已經建成擁有普通微生物菌種庫和13個專業菌種庫的華南地區... 質量目標 科學、公正、準確、周到地為客戶提供高質量的服務 普通微生物菌種...
簡介 服務宗旨 質量目標 普通微生物菌種庫 專業微生物菌種庫。預防護理加強體質鍛鍊,加強營養,增強人體抗病能力。病理病因馬內菲青黴是惟一的原發致病菌,其為雙相菌。其他已知致病的有橘青黴、產黃青黴、擴展青黴、斜臥青黴和軟毛青黴(亦名普通青黴)。疾病診斷青黴菌病需與麴黴病相鑑別。取...
症狀體徵 用藥治療 飲食保健 預防護理 病理病因氨基甲醯基]-吡咯烷基-4-硫代]-6-(1-羥乙基)-1-甲基碳青黴烯...
基本信息 使用方法